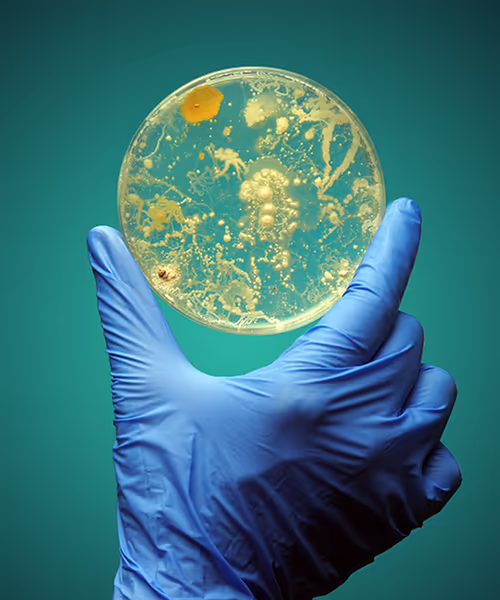

Protect Your Passengers with Pace®
Pace® offers comprehensive Legionella testing services to help cruise ship operators identify and mitigate the risk of legionellosis, also referred to as Legionnaires’ disease or Legionella pneumonia. Frequent water system testing—including hot tubs, spas, and showers—is critical because these environments can promote the growth of Legionella bacteria, leading to outbreaks of this common disease on ships. By partnering with Pace®, cruise lines can ensure timely detection and rapid response, protecting passengers and crew from legionellosis, supporting compliance with health and safety regulations, and preserving market reputation.


What is Legionella?
Legionella is a type of bacteria commonly found in freshwater environments, such as lakes and streams. However, it can become a serious health concern when it grows and spreads in manmade water systems, including those found on cruise ships. The bacteria thrive in warm water settings like hot tubs, spas, showers, and decorative fountains, making these areas potential sources for outbreaks of Legionnaires’ disease—a severe form of pneumonia caused by inhaling water droplets containing Legionella. Because cruise ships feature complex water systems and serve large groups of people in close quarters, they are particularly vulnerable to the rapid spread of this infection.
Frequently Asked Questions: Legionella on Cruise Ships
It’s crucial for cruise ship operators to get the facts about Legionella so they can make informed decisions to protect the health of passengers and crew. Here are answers to some of the most common questions we hear. If you don’t see what you’re looking for, please reach out to us.

A study of water samples from 9 vessels, 42% were found to contain Legionella. When Legionella infections occur onboard cruise ships, they can have significant health impacts due to the close quarters and shared water systems. The Centers for Disease Control and Prevention (CDC) and other health authorities have documented several incidents over the years, highlighting the importance of ongoing vigilance. While not an everyday occurrence, the risk is persistent enough that cruise operators must implement strict water management and monitoring protocols to prevent and control potential outbreaks.
Legionnaires’ disease is a severe form of pneumonia, but it is part of a broader group of illnesses known as legionellosis. Legionellosis encompasses both Legionnaires’ disease and a milder infection called Pontiac fever, which can cause flu-like symptoms without pneumonia.
After exposure to Legionella bacteria, symptoms typically begin to appear within 2 to 10 days in sensitive individuals, with most cases developing around 5 to 6 days after contact with contaminated water sources. Early signs often include fever, chills, muscle aches, and headache, followed by cough and shortness of breath as the illness progresses. Prompt recognition of these symptoms is essential for timely diagnosis and treatment, especially in cruise ship environments where rapid response can help prevent further spread.
Legionella bacteria can colonize several types of water systems on cruise ships. As with hospitality more broadly, hot tub infections are prime suspects in an outbreak. However, anywhere water is stored or circulated at temperatures between 77°F and 113°F can become a hot spot for Legionella growth.
While hot tubs, showers, and decorative fountains are commonly recognized as high-risk areas, ice machines are another potential hot spot that many people overlook. Even though ice machines operate at cooler temperatures, they can harbor biofilms in internal mechanisms and water lines, especially if left unused or not regularly sanitized. These biofilms can support the survival and proliferation of Legionella, posing a risk whenever ice is used in food or drinks on board.
Cooling towers on cruise ships can also pose a risk for Legionella growth, especially if they are part of traditional open or closed-loop systems that utilize fresh water. These systems can create the warm, moist environments that Legionella bacteria favor, particularly if maintenance lapses allow biofilms and scale to accumulate. In contrast, seawater heat exchangers are generally considered to pose a lower risk for Legionella proliferation because the higher salinity and different chemical composition of seawater are less conducive to bacterial survival.
Inadequate maintenance of these water systems is a key factor that allows the bacteria to flourish. In addition, periods of disuse—such as when certain facilities are not used for extended stretches—enable the formation of biofilms inside pipes and equipment, which provide a protective environment where Legionella and other waterborne pathogens can multiply.
It is possible, but not common, for passengers and crew to become ill from drinking water contaminated with Legionella. The primary route of infection is through the inhalation of tiny water droplets (aerosols) that contain Legionella bacteria. While drinking contaminated water is less likely to lead to illness, it can still pose a risk, particularly when individuals with weakened immune systems, underlying lung conditions, or other vulnerabilities inadvertently aspirate (breathe in) water droplets while drinking. Maintaining clean, properly treated water systems on cruise ships is critical for minimizing all possible routes of Legionella exposure, not to mention exposure to other waterborne pathogens.
Health authorities, such as the U.S. Centers for Disease Control and Prevention (CDC) Vessel Sanitation Program (VSP), provide specific recommendations for the monitoring and management of onboard water systems, including routine testing for Legionella bacteria. Additionally, the World Health Organization (WHO) offers guidance on ship sanitation to control Legionella and other waterborne pathogens. Compliance with these standards is essential for protecting passenger and crew health and is often required for ships operating in U.S. waters or under certain international flags.
National and regional authorities may also impose their own requirements, so cruise operators must stay informed of the latest legal obligations and best practices. Water management plans that include regular documentation, testing schedules, and evidence of corrective actions are typically required to demonstrate compliance during inspections. These measures are designed to ensure that potential Legionella risks are identified and managed proactively, minimizing the likelihood of outbreaks on board.
Pace® offers comprehensive Legionella Outbreak Response services designed to support cruise ship operators in the event of suspected Legionella detection. This team can be reached 24/7 at 412-281-5335. To discuss routine testing for Legionella and other waterborne pathogens or explore our water management planning services, contact the Pace® Building Sciences team.
Passengers can play a role in helping to prevent a Legionella outbreak by staying informed and practicing good hygiene while onboard. For example, they should avoid tampering with water system fixtures, promptly report any issues with water quality (such as unusual taste, odor, or discoloration), and follow posted guidelines regarding the use of showers, hot tubs, and other water features. Additionally, individuals with higher risk factors should take extra precautions, such as avoiding aerosol-generating activities or areas with stagnant water. By remaining vigilant and communicating concerns to ship staff, passengers contribute to the overall safety and health of everyone on the vessel.
Legionella Emergency Response Services
The Pace® emergency response team includes experts in microbiology, engineering, water treatment, infection prevention, communication, public health, and medicine. Together, they provide the wide range of skills needed to manage all parts of a Legionella outbreak, including:
- High Quality Outbreak Response Management
- Coordinate Emergency Disinfection
- Onsite Sampling and Risk Assessment
- Case Investigation Laboratory Services
- Laboratory Results Interpretation
- Liaison with Health Department
- Staff and Townhall Meetings
- Communication Strategies; Media and Public Relations
- Recommendations for Ongoing Disinfection
If you suspect a Legionella outbreak, call us 24/7 at 412-281-5335.
How to do Legionella Testing:
PCR, Culture, CDC & ISO Methods

Water Management Planning
Water management planning can help cruise ship operators develop effective strategies for monitoring, controlling, and reducing the risk of Legionella and other waterborne pathogens. These plans typically outline procedures for regular inspection, maintenance, and disinfection of various water systems, including hot tubs, decorative water features, ice machines, cooling towers, and other Legionella hot spots. By identifying potential risk areas and establishing preventative measures and corrective protocols, water management planning helps cruise ship operators comply with health regulations and protect passengers and crew from illnesses caused by waterborne pathogens.